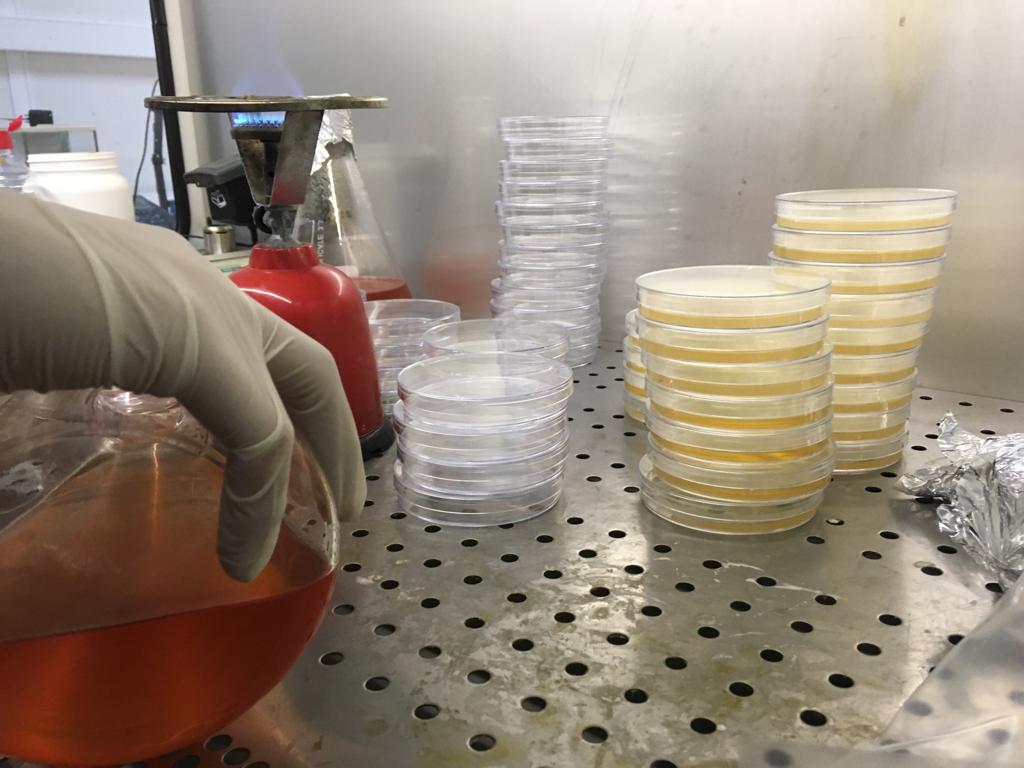
Currently at the Agricultural University of Athens - working on the isolation of bacteria from the #Frankia #nodules of #alder (#Alnus) trees in the permafrost region of Mohe, Northeast China.

Elisabeth Ramm
@ramm_elisabeth
PhD Student
Karlsruhe Institute of Technology (KIT)
Institute of Meteorology and Climate Research
Atmospheric Environmental Research (IMK-IFU)
ID: 110212603
https://www.researchgate.net/profile/Elisabeth_Ramm 31-01-2010 19:18:48
55 Tweet
71 Takipçi
115 Takip Edilen


Our study showed surprisingly high nitrogen turnover in permafrost. A review of the importance of mineral nitrogen cycling in the plant-soil-microbe system of permafrost-affected soils—changing the paradigm doi.org/10.1088/1748-9… via IOPscience






Wenn die BReg ihre gern gepflegte Menschenrechtsrhetorik &den Einsatz für #Pressefreiheit ansatzweise ernst meint, muss sie jetzt endlich sofort tätig werden &alles dafür tun, die drohende Auslieferung von #Assange an die USA zu verhindern! #FreeAssangeNow spiegel.de/ausland/britis…





"To replicate, or not to replicate – that is the question: how to tackle nonlinear responses in ecological experiments" — Read it on ResearchGate: researchgate.net/publication/32…




‘Stop Congratulating Colleagues for Publishing in High Impact-Factor Journals’ science.thewire.in/the-sciences/b… via The Wire Science